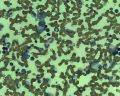
תמונה ממוזערת לגרסה מ־16:07, 5 בפברואר 2026

קובץ:Marrow Follicullar lymphoma.jpg
מתוך ויקירפואה

גודל התצוגה המקדימה הזאת: 750 × 600 פיקסלים. רזולוציות אחרות: 300 × 240 פיקסלים | 960 × 768 פיקסלים.
לקובץ המקורי (960 × 768 פיקסלים, גודל הקובץ: 183 קילו־בייטים, סוג MIME: image/jpeg)
היסטוריית הקובץ
ניתן ללחוץ על תאריך/שעה כדי לראות את הקובץ כפי שנראה באותו זמן.
| תאריך/שעה | תמונה ממוזערת | ממדים | משתמש | הערה | |
|---|---|---|---|---|---|
| נוכחית | 16:07, 5 בפברואר 2026 | | 960 × 768 (183 קילו־בייטים) | Motyk (שיחה | תרומות) |
אין באפשרותך לדרוס את הקובץ הזה.
שימוש בקובץ
הדף הבא משתמש בקובץ זה:


 כניסה
כניסה  עקבו אחרינו בפייסבוק
עקבו אחרינו בפייסבוק